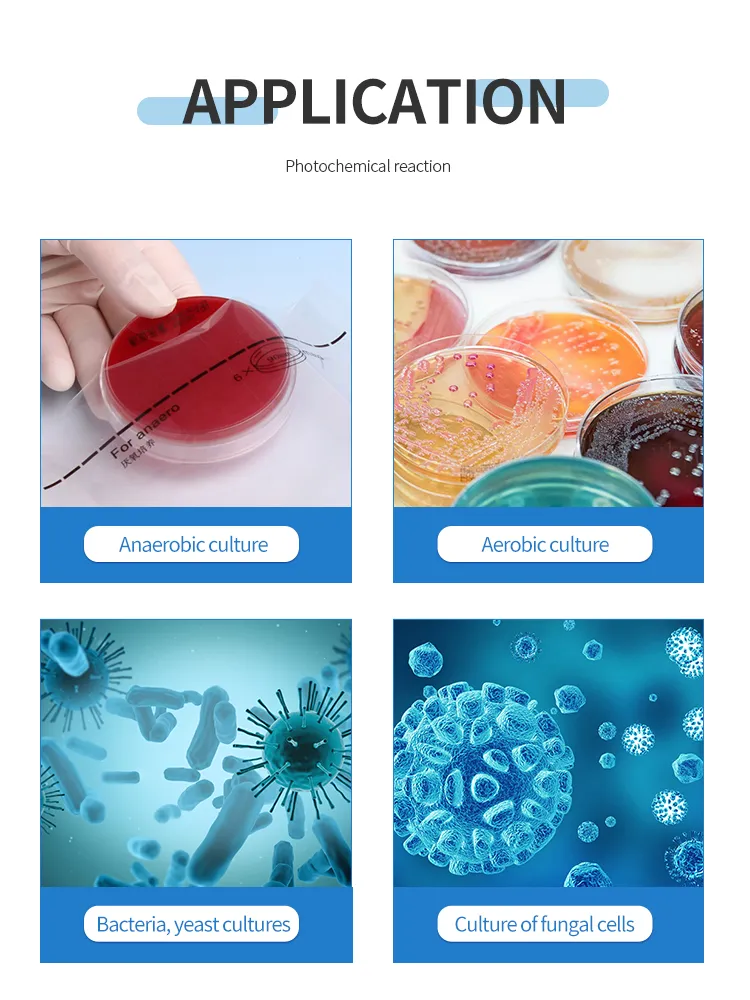

Product









Preview
Basic Info.Product DescriptionCertifications
Basic Info.
Model NO. | KDBIO-10/20/50/100L/500L/1000L/5000L |
Material | SS316L+Borosilicate Glass |
Capacity | 10/20/50/100L/500L/1000L/5000L |
Pressure | Positive |
Agitator Model | Combined Agitator |
Tower Reactor Type | Fermentor Bioreactor |
Heating | Electric Heating |
Heat Transfer Structure | Combined |
Automatic Grade | Semi-Automatic |
Condition | New |
Product Name | Benchtop Bioreactor Price 2L 5L Bioreactor Price |
Tank Volume | 0.5/5/10/20/50/100L/500L/1000L/5000L |
Aspect Ratio | 1:2-3 |
Filling Coefficient | 65%-80% |
Power Supply | 220VAC, 50/60Hz, 10A |
Base | 304 Stainless Steel Case with Coating. |
Interface | Quick Connect Aviation Plug/USB Interface |
Sterilization Method | in-Situ or Ex-Situ Sterilization |
Stirring System | Mechanical Stirring or Bottom Magnetic Stirring |
Measuring Range | 0-100% or 0-200% |
Control Accuracy | ±3% |
Resolution | 0.1% |
Transport Package | Wooden Case |
Trademark | ZZKD |
Package Size | 80.00cm * 60.00cm * 120.00cm |
Package Gross Weight | 100.000kg |
Package Size | 80.00cm * 60.00cm * 120.00cm |
Package Gross Weight | 100.000kg |
Product Description
Lab Scale Bioreactor Laboratory Small Glass Bioreactor Fermenter Benchtop Bioreactor Price 2L 5L Bioreactor Price
Preview
Product Description
Preview
The glass bioreactor is one of the important types of glass reactors. And it is a vessel used to carry out the biological reaction. Some of the applications of the bioreactor include the culture of aerobic cells in conducting cellular and enzymatic immobilization processes. Living organisms are used to synthesize substances in the bioreactor.
Preview

Preview

Preview

Preview

Preview

Preview
Preview

Preview

Preview
Company Profile
Preview
Zhengzhou Keda Machinery and Instrument Equipment Co., Ltd. is specialized in R & D, production, sales, teaching and chemical biology pharmacy equipment integrated company. The main products are rotary evaporator, jacketed glass reactor, single layer glass reactor,
circulating water vacuum pump, low-temperature reaction bath (slot), low temperature cooling fluid circulating pump(cool chiller), vacuum drying oven, blast drying oven, freeze dryer, water/oil bath, magnetic heating stirrer,
overhead mixer, ultrasonic cleaning machine, lift platform, etc. Besides, we act as agents of some domestic and foreign famous enterprise products, sustaining high praise in domestic junior colleges and universities, scientific research units, etc. Our products are sold to USA, Australia, Asia, Brazil, Iran, Egypt, etc. countries and our customers have been fully affirmation.
circulating water vacuum pump, low-temperature reaction bath (slot), low temperature cooling fluid circulating pump(cool chiller), vacuum drying oven, blast drying oven, freeze dryer, water/oil bath, magnetic heating stirrer,
overhead mixer, ultrasonic cleaning machine, lift platform, etc. Besides, we act as agents of some domestic and foreign famous enterprise products, sustaining high praise in domestic junior colleges and universities, scientific research units, etc. Our products are sold to USA, Australia, Asia, Brazil, Iran, Egypt, etc. countries and our customers have been fully affirmation.
Preview

Preview

Preview

Preview

Preview

Preview

Preview

Preview
Factory Size: 1,000-3,000 square meters
Year Established: 2009
Total Revenue: US$1 Million - US$2.5 Million
Registration No.: 410105000067362
Main Markets: Central America, Mid East, Oceania, Africa, South America
Year Established: 2009
Total Revenue: US$1 Million - US$2.5 Million
Registration No.: 410105000067362
Main Markets: Central America, Mid East, Oceania, Africa, South America
Preview

Preview

Preview
Packaging:
-After use cartons inside, outside with wooden case packaging;
-Both neutral and customized packaging can be available.Shipping:
-We can ship the goods to you by International Express such as DHL, TNT, EMS, FedEx and so on and you can also choose the appropriate one based on your timeline and budget. Besides, you can definitely choose to use your own shipping agent.
Shipping method
Note
Express
Door to door, very convenient, don't need to clearance or pick-up
By air
Airport to an airport, you need to do the customs clearance and pick up the goods at your local airport, which you can have a local shipping agent to do for you.
By sea
Port to port and you need to do the customs clearance and pick-up the goods at your local port, which you can have a local shipping agent to do for you.
Pre-sale Service:
--24 Hours online service for your consultation.
--Help choose right model, and a series of services, people, and advice.
--Give you the best offer.
--Provide discount for many sets order.
--Do customer's request.
--Choose payment term you convenient.
--Promptly production and delivery, inform you in time.
--Can provide invoice value as you like to decrease your tax.After-sale service:
--1 year warranty service and all life maintenance.
--Technical Engineers are available for overseas training.
--Remote control technical consult.
--Free installation DVD.
--Maintenance plan.
-After use cartons inside, outside with wooden case packaging;
-Both neutral and customized packaging can be available.Shipping:
-We can ship the goods to you by International Express such as DHL, TNT, EMS, FedEx and so on and you can also choose the appropriate one based on your timeline and budget. Besides, you can definitely choose to use your own shipping agent.
Shipping method
Note
Express
Door to door, very convenient, don't need to clearance or pick-up
By air
Airport to an airport, you need to do the customs clearance and pick up the goods at your local airport, which you can have a local shipping agent to do for you.
By sea
Port to port and you need to do the customs clearance and pick-up the goods at your local port, which you can have a local shipping agent to do for you.
Pre-sale Service:
--24 Hours online service for your consultation.
--Help choose right model, and a series of services, people, and advice.
--Give you the best offer.
--Provide discount for many sets order.
--Do customer's request.
--Choose payment term you convenient.
--Promptly production and delivery, inform you in time.
--Can provide invoice value as you like to decrease your tax.After-sale service:
--1 year warranty service and all life maintenance.
--Technical Engineers are available for overseas training.
--Remote control technical consult.
--Free installation DVD.
--Maintenance plan.
Preview
FAQ
Preview
1. What's the minimum order quantity?
One set at present.
2. What kind of payment terms do you accept?
Normally we accept TT, Paypal, Western Union, and L/C. The exact term will be discussed during the deal.
3. How will you deliver these goods?
It will be decided according to your quantity. Normally we will choose International Express, Air and sea.
4. How will we package glass equipment be?
We package these glass equipment in good and Nonfumigation standard wooden cases.
5. Can you accept OEM terms?
Sure.
6. How to choose suitable equipment?
You tell us your requirements (For example capacity, temperature range, pressure, etc ), we will recommend you the best suitable equipment.
One set at present.
2. What kind of payment terms do you accept?
Normally we accept TT, Paypal, Western Union, and L/C. The exact term will be discussed during the deal.
3. How will you deliver these goods?
It will be decided according to your quantity. Normally we will choose International Express, Air and sea.
4. How will we package glass equipment be?
We package these glass equipment in good and Nonfumigation standard wooden cases.
5. Can you accept OEM terms?
Sure.
6. How to choose suitable equipment?
You tell us your requirements (For example capacity, temperature range, pressure, etc ), we will recommend you the best suitable equipment.
Preview
Certifications
Name:证书



Preview
Lab Scale Bioreactor Laboratory Small Glass Bioreactor Fermenter Benchtop Bioreactor Price 2L 5L Bioreactor Price
$9455 ~ $13462.81
Chemical industry chain · Chemical equipment and machinery · Chemical Reactor
Model NO.:KDBIO-10/20/50/100L/500L/1000L/5000L
Transport Package:Wooden Case


Less than 50 EmployeesWholesale/Retail/New Retail